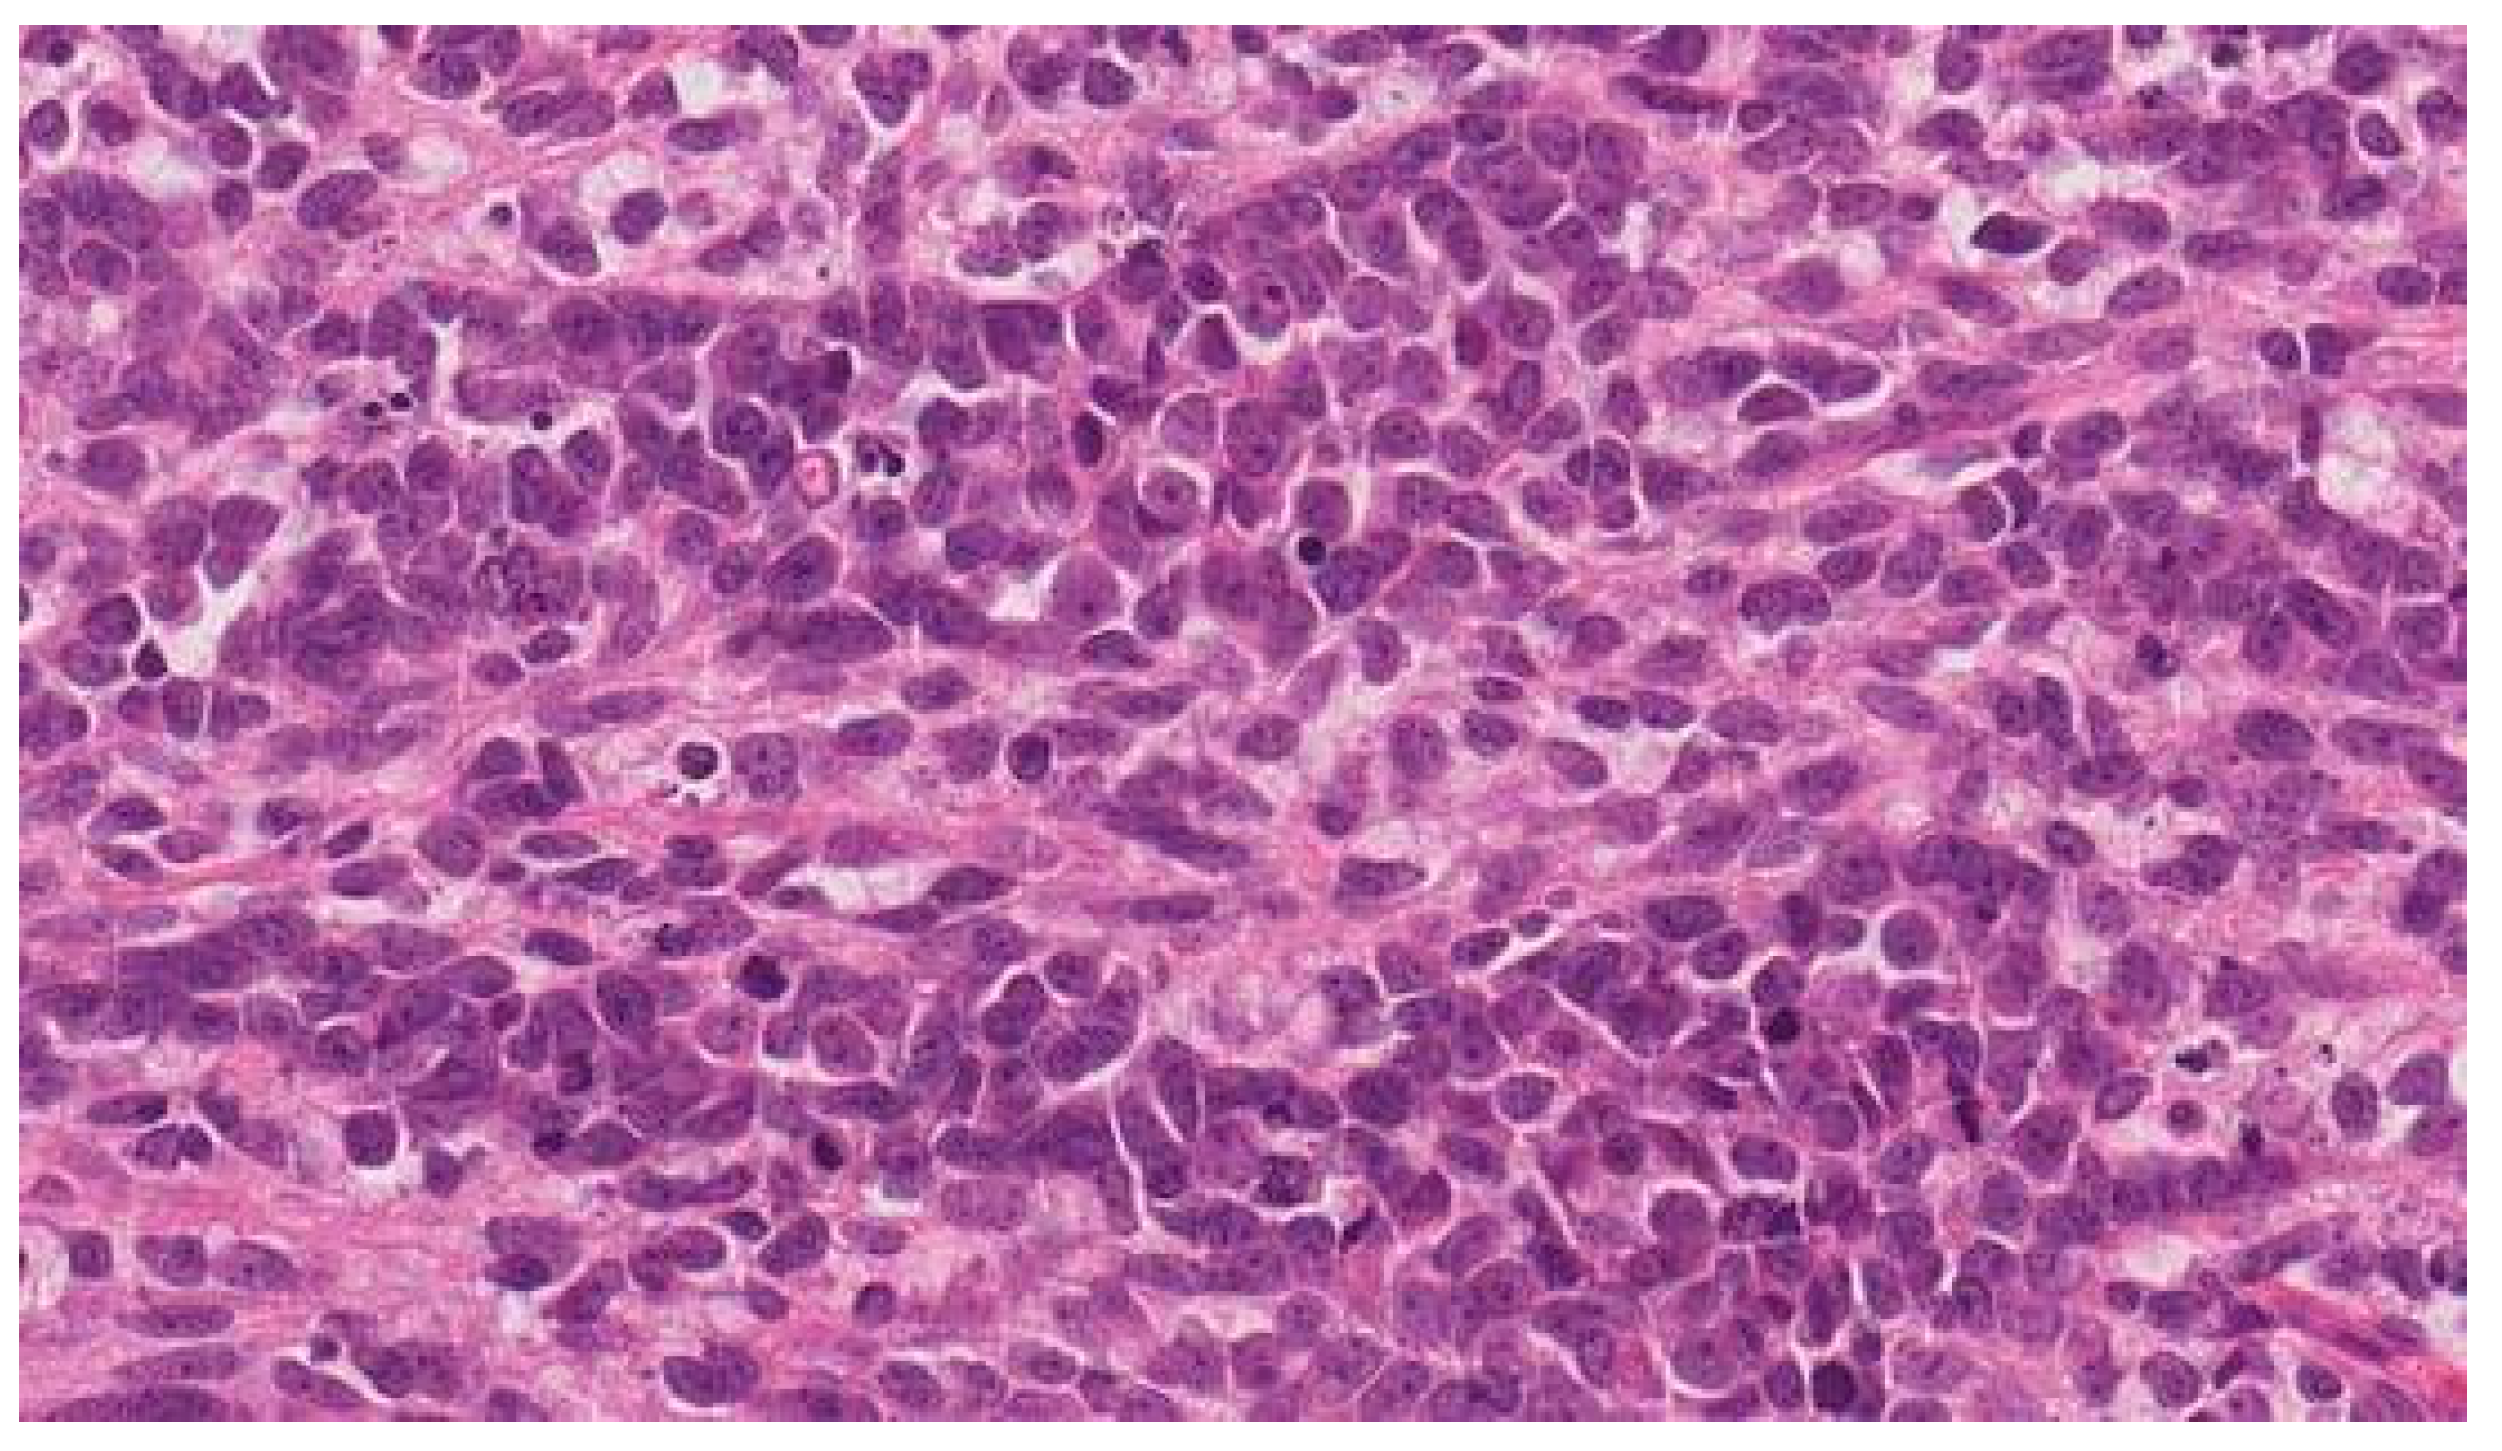
Medicina 59 00995 g005

Multiple Rare Primary Malignancies: A Mixed Squamous Neuroendocrine Adenocarcinoma of the Cervix, Metastasized Carcinosarcoma and Extramammary Vulvar Paget’s Disease Case Report
Abstract
1. Introduction
2. Case Report
3. Discussion
4. Conclusions
Author Contributions
Funding
Institutional Review Board Statement
Informed Consent Statement
Data Availability Statement
Acknowledgments
Conflicts of Interest
References
- Demandante, C.G.N.; Troyer, D.A.; Miles, T.P. Multiple Primary Malignant Neoplasms: Case Report and a Comprehensive Review of the Literature. Am. J. Clin. Oncol. 2003, 26, 79–83. [Google Scholar] [CrossRef] [PubMed]
- Wood, M.E.; Vogel, V.; Ng, A.; Foxhall, L.; Goodwin, P.; Travis, L.B. Second Malignant Neoplasms: Assessment and Strategies for Risk Reduction. J. Clin. Oncol. Off. J. Am. Soc. Clin. Oncol. 2012, 30, 3734–3745. [Google Scholar] [CrossRef] [PubMed]
- Schottenfeld, D.; Beebe-Dimmer, J.L. Multiple Primary Cancers. In Cancer Epidemiology and Prevention; Schottenfeld, D., Fraumeni, J.F., Eds.; Oxford University Press: Oxford, UK, 2006; ISBN 978-0-19-514961-6. [Google Scholar]
- New Malignancies among Cancer Survivors—SEER Cancer Registries, 1973–2000—SEER Publications. Available online: https://seer.cancer.gov/archive/publications/mpmono/ (accessed on 30 October 2022).
- Vogt, A.; Schmid, S.; Heinimann, K.; Frick, H.; Herrmann, C.; Cerny, T.; Omlin, A. Multiple Primary Tumours: Challenges and Approaches, a Review. ESMO Open 2017, 2, e000172. [Google Scholar] [CrossRef] [PubMed]
- Copur, M.S.; Manapuram, S. Multiple Primary Tumors Over a Lifetime. Oncology 2019, 33, 629384. [Google Scholar] [PubMed]
- Poh, C.; Keegan, T.; Rosenberg, A.S. Second Primary Malignancies in Multiple Myeloma: A Review. Blood Rev. 2021, 46, 100757. [Google Scholar] [CrossRef]
- Lv, M.; Zhang, X.; Shen, Y.; Wang, F.; Yang, J.; Wang, B.; Chen, Z.; Li, P.; Zhang, X.; Li, S.; et al. Clinical Analysis and Prognosis of Synchronous and Metachronous Multiple Primary Malignant Tumors. Medicine 2017, 96, e6799. [Google Scholar] [CrossRef]
- Babacan, N.; Aksoy, S.; Çetin, B.; Ozdemir, N.; Benekli, M.; Üyetürk, Ü.; Kaplan, M.A.; Kos, F.T.; Karaca, H.; Oksuzoglu, B.; et al. Multiple Primary Malignant Neoplasms: Multi-Center Results from Turkey. J. BUON Off. J. Balk. Union Oncol. 2012, 17, 770–775. [Google Scholar]
- Yang, E.-J.; Lee, J.-H.; Lee, A.-J.; Kim, N.-R.; Ouh, Y.-T.; Kim, M.-K.; Shim, S.-H.; Lee, S.-J.; Kim, T.-J.; So, K.-A. Multiple Primary Malignancies in Patients with Gynecologic Cancer. J. Clin. Med. 2021, 11, 115. [Google Scholar] [CrossRef]
- Travis, L.B.; Rabkin, C.S.; Brown, L.M.; Allan, J.M.; Alter, B.P.; Ambrosone, C.B.; Begg, C.B.; Caporaso, N.; Chanock, S.; DeMichele, A.; et al. Cancer Survivorship—Genetic Susceptibility and Second Primary Cancers: Research Strategies and Recommendations. JNCI J. Natl. Cancer Inst. 2006, 98, 15–25. [Google Scholar] [CrossRef]
- Goecke, T.; Schulmann, K.; Engel, C.; Holinski-Feder, E.; Pagenstecher, C.; Schackert, H.K.; Kloor, M.; Kunstmann, E.; Vogelsang, H.; Keller, G.; et al. Genotype-Phenotype Comparison of German MLH1 and MSH2 Mutation Carriers Clinically Affected With Lynch Syndrome: A Report by the German HNPCC Consortium. J. Clin. Oncol. 2006, 24, 4285–4292. [Google Scholar] [CrossRef]
- La Rosa, S.; Marando, A.; Sessa, F.; Capella, C. Mixed Adenoneuroendocrine Carcinomas (MANECs) of the Gastrointestinal Tract: An Update. Cancers 2012, 4, 11–30. [Google Scholar] [CrossRef]
- Dewi, I.G.A.S.M. Uterine Cervix Mixed Adenoneuroendocrine Carcinoma: Case Report of a Rare, High Grade and Aggressive Tumor. Bali Med. J. 2020, 9, 587–590. [Google Scholar] [CrossRef]
- Solcia, E.; Klöppel, G.; Sobin, L.H. Histological Typing of Endocrine Tumours, 2nd ed.; Springer Science & Business Media: Berlin, Germany, 2012; ISBN 978-3-642-59655-1. [Google Scholar]
- Stelow, E.B.; Moskaluk, C.A.; Mills, S.E. The Mismatch Repair Protein Status of Colorectal Small Cell Neuroendocrine Carcinomas. Am. J. Surg. Pathol. 2006, 30, 1401–1404. [Google Scholar] [CrossRef] [PubMed]
- Brathwaite, S.A.; Smith, S.M.; Wai, L.; Frankel, W.; Hays, J.; Yearsley, M.M.; Abdel-Misih, S. Mixed Adenoneuroendocrine Carcinoma: A Review of Pathologic Characteristics. Hum. Pathol. 2018, 73, 184–191. [Google Scholar] [CrossRef] [PubMed]
- Kim, G.E.; Lee, S.W.; Suh, C.O.; Park, T.K.; Kim, J.W.; Park, J.T.; Shim, J.U. Hepatic Metastases from Carcinoma of the Uterine Cervix. Gynecol. Oncol. 1998, 70, 56–60. [Google Scholar] [CrossRef] [PubMed]
- Ribeiro-Silva, A.; Novello-Vilar, A.; Cunha-Mercante, A.M.; De Angelo Andrade, L.A.L. Malignant Mixed Mullerian Tumor of the Uterine Cervix with Neuroendocrine Differentiation. Int. J. Gynecol. Cancer Off. J. Int. Gynecol. Cancer Soc. 2002, 12, 223–227. [Google Scholar] [CrossRef]
- Wright, J.D.; Rosenblum, K.; Huettner, P.C.; Mutch, D.G.; Rader, J.S.; Powell, M.A.; Gibb, R.K. Cervical Sarcomas: An Analysis of Incidence and Outcome. Gynecol. Oncol. 2005, 99, 348–351. [Google Scholar] [CrossRef]
- Soslow, R.A. Mixed Müllerian Tumors of the Female Genital Tract. Surg. Pathol. Clin. 2009, 2, 707–730. [Google Scholar] [CrossRef]
- Clement, P.B.; Zubovits, J.T.; Young, R.H.; Scully, R.E. Malignant Mullerian Mixed Tumors of the Uterine Cervix: A Report of Nine Cases of a Neoplasm with Morphology Often Different from Its Counterpart in the Corpus. Int. J. Gynecol. Pathol. Off. J. Int. Soc. Gynecol. Pathol. 1998, 17, 211–222. [Google Scholar] [CrossRef]
- Munakata, S.; Iwai, E.; Tanaka, T.; Nakamura, M.; Kanda, T. Malignant Müllerian Mixed Tumor of the Uterine Cervix with a Small Cell Neuroendocrine Carcinoma Component. Case Rep. Pathol. 2013, 2013, 630859. [Google Scholar] [CrossRef]
- Zhang, Q.; Liu, A.; Wu, J.J.; Niu, M.; Zhao, Y.; Tian, S.F.; Chen, A.; Zhong, L. Primary Malignant Mixed Müllerian Tumors of the Fallopian Tube with Cervix Metastasis. Medicine 2018, 97, e11311. [Google Scholar] [CrossRef] [PubMed]
- Cormio, G.; Colamaria, A.; Di Vagno, G.; Pierangeli, E.; Vailati, G.; Selvaggi, L. Central Nervous System Involvement Secondary to Metastatic Mixed Müllerian Tumor of the Uterus. Gynecol. Obstet. Investig. 1997, 44, 214–216. [Google Scholar] [CrossRef]
- Ulbricht, L.J.; Kunert, M.; Gremmler, B.; Evagelopoulos, N.; Krian, A.; Moege, J. Intracardiac Metastasis of a Malignant Mixed Mullerian Tumor (MMMT): Progressive Dyspnoea Due to Obstruction of the Left Atrium and the Left Ventricle without Left Ventricular Dysfunction or Primary Lung Disease. Wien. Med. Wochenschr. 2009, 159, 355–358. [Google Scholar] [CrossRef] [PubMed]
- Komatsubara, T.; Koinuma, K.; Miyakura, Y.; Horie, H.; Morimoto, M.; Ito, H.; Lefor, A.K.; Sata, N.; Fukushima, N. Endocrine Cell Carcinomas of the Colon and Rectum: A Clinicopathological Evaluation. Clin. J. Gastroenterol. 2016, 9, 1–6. [Google Scholar] [CrossRef]
- Ahlman, H.; Nilsson, O.; McNicol, A.M.; Ruszniewski, P.; Niederle, B.; Ricke, J.; Jensen, R.; Kos-Kudła, B.; Oberg, K.; O’Connor, J.M.; et al. Poorly-Differentiated Endocrine Carcinomas of Midgut and Hindgut Origin. Neuroendocrinology 2008, 87, 40–46. [Google Scholar] [CrossRef] [PubMed]
- Md, M.R.N.; Md, E.O. Gynecologic Pathology: A Volume in the Series: Foundations in Diagnostic Pathology; Elsevier Health Sciences: Amsterdam, The Netherlands, 2009; ISBN 978-0-443-06920-8. [Google Scholar]
- Tao, W.; Yang, J.; Jiang, Y.; Chen, W.; Wang, Y. Paclitaxel, Carboplatin, and Bevacizumab in Advanced Cervical Cancer: A Treatment Response and Safety Analysis. Dose-Response 2020, 18, 1559325820941351. [Google Scholar] [CrossRef] [PubMed]
- Pignata, S.; Scambia, G.; Katsaros, D.; Gallo, C.; Pujade-Lauraine, E.; De Placido, S.; Bologna, A.; Weber, B.; Raspagliesi, F.; Panici, P.B.; et al. Carboplatin plus Paclitaxel Once a Week versus Every 3 Weeks in Patients with Advanced Ovarian Cancer (MITO-7): A Randomised, Multicentre, Open-Label, Phase 3 Trial. Lancet Oncol. 2014, 15, 396–405. [Google Scholar] [CrossRef]
- Ranpura, V.; Hapani, S.; Wu, S. Treatment-Related Mortality with Bevacizumab in Cancer Patients: A Meta-Analysis. JAMA 2011, 305, 487–494. [Google Scholar] [CrossRef]
- Kurata, T.; Nakagawa, K. Efficacy and Safety of Denosumab for the Treatment of Bone Metastases in Patients with Advanced Cancer. Jpn. J. Clin. Oncol. 2012, 42, 663–669. [Google Scholar] [CrossRef]
- Cancer of the Cervix Uteri—Cancer Stat Facts. Available online: https://seer.cancer.gov/statfacts/html/cervix.html (accessed on 11 May 2023).
- Kimyon Comert, G.; Turkmen, O.; Karalok, A.; Basaran, D.; Bulbul, D.; Turan, T. Therapy Modalities, Prognostic Factors, and Outcome of the Primary Cervical Carcinosarcoma: Meta-Analysis of Extremely Rare Tumor of Cervix. Int. J. Gynecol. Cancer Off. J. Int. Gynecol. Cancer Soc. 2017, 27, 1957–1969. [Google Scholar] [CrossRef]

Disclaimer/Publisher’s Note: The statements, opinions and data contained in all publications are solely those of the individual author(s) and contributor(s) and not of MDPI and/or the editor(s). MDPI and/or the editor(s) disclaim responsibility for any injury to people or property resulting from any ideas, methods, instructions or products referred to in the content. |
© 2023 by the authors. Licensee MDPI, Basel, Switzerland. This article is an open access article distributed under the terms and conditions of the Creative Commons Attribution (CC BY) license (https://creativecommons.org/licenses/by/4.0/).
Share and Cite
Andreika, L.; Vankevičienė, K.; Plioplytė, M.; Bitinaitytė, M.; Rudaitis, V. Multiple Rare Primary Malignancies: A Mixed Squamous Neuroendocrine Adenocarcinoma of the Cervix, Metastasized Carcinosarcoma and Extramammary Vulvar Paget’s Disease Case Report. Medicina 2023, 59, 995. https://doi.org/10.3390/medicina59050995
Andreika L, Vankevičienė K, Plioplytė M, Bitinaitytė M, Rudaitis V. Multiple Rare Primary Malignancies: A Mixed Squamous Neuroendocrine Adenocarcinoma of the Cervix, Metastasized Carcinosarcoma and Extramammary Vulvar Paget’s Disease Case Report. Medicina. 2023; 59(5):995. https://doi.org/10.3390/medicina59050995
Chicago/Turabian StyleAndreika, Linas, Karolina Vankevičienė, Marija Plioplytė, Monika Bitinaitytė, and Vilius Rudaitis. 2023. "Multiple Rare Primary Malignancies: A Mixed Squamous Neuroendocrine Adenocarcinoma of the Cervix, Metastasized Carcinosarcoma and Extramammary Vulvar Paget’s Disease Case Report" Medicina 59, no. 5: 995. https://doi.org/10.3390/medicina59050995
APA StyleAndreika, L., Vankevičienė, K., Plioplytė, M., Bitinaitytė, M., & Rudaitis, V. (2023). Multiple Rare Primary Malignancies: A Mixed Squamous Neuroendocrine Adenocarcinoma of the Cervix, Metastasized Carcinosarcoma and Extramammary Vulvar Paget’s Disease Case Report. Medicina, 59(5), 995. https://doi.org/10.3390/medicina59050995

